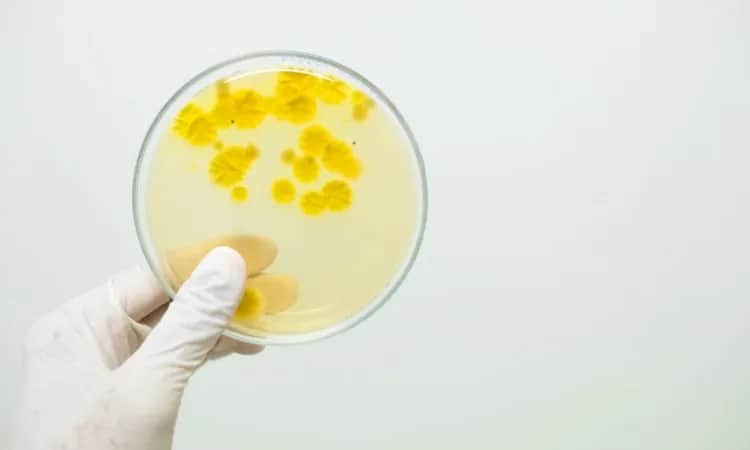
Bakterie w moczu - co oznacza wynik "bardzo liczne"?

Poznaj skuteczne sposoby leczenia zakażenia candida albicans. Dowiedz się, jak pozbyć się uciążliwych objawów grzybicy przy pomocy leków i naturalnych metod. Czy candida non albicans to również problem? Wszystko o przyczynach i czynnikach ryzyka.
Jestem założycielem i głównym autorem portalu o zdrowiu, który powstał z mojej pasji do medycyny i zdrowego stylu życia. Jako wykwalifikowany dietetyk z wieloletnim doświadczeniem, postanowiłem dzielić się wiedzą, która pomaga ludziom żyć pełniej i zdrowiej. Moja misja to dostarczanie rzetelnych, opartych na badaniach informacji o żywieniu, fitnessie i zdrowiu psychicznym. Wierzę, że każdy ma prawo do dostępu do wiedzy, która może znacząco poprawić jakość życia. Dążę do tego, by mój portal był miejscem, gdzie czytelnicy znajdą praktyczne porady, inspiracje oraz wsparcie w dążeniu do lepszego zdrowia.

Poznaj skuteczne sposoby leczenia zakażenia candida albicans. Dowiedz się, jak pozbyć się uciążliwych objawów grzybicy przy pomocy leków i naturalnych metod. Czy candida non albicans to również problem? Wszystko o przyczynach i czynnikach ryzyka.

Celiakia to choroba autoimmunologiczna wywołana nietolerancją glutenu. Poznaj charakterystyczne objawy celiakii, w tym dolegliwości żołądkowo-jelitowe, niedobory i kluczowe informacje o leczeniu

Odkryj przyczyny bólu brzucha i klatki piersiowej - od niegroźnych po zagrażające życiu. Dowiedz się, które objawy wymagają natychmiastowej pomocy medycznej. Poznaj skuteczne sposoby radzenia sobie z tymi dolegliwościami.

Poznaj przyczyny częstego bulgotania w brzuchu i nadmiernej ilości gazów. Nietolerancje pokarmowe, zaburzona flora bakteryjna czy schorzenia układu trawiennego - dowiedz się więcej.
Dowiedz się, co oznaczają bakterie w moczu d liczne - wynik sugerujący groźną infekcję układu moczowego. Poznaj przyczyny, objawy i sposoby leczenia.

Dowiedz się, jak leczyć bakteryjne zapalenie skóry i jelit za pomocą antybiotyków, ziół i zmian w diecie. Skuteczne metody przemywania ran i zapobiegania infekcjom.

Biegunka po antybiotyku czy probiotyku to częsty efekt uboczny tych preparatów. Poznaj przyczyny i sposoby na zminimalizowanie ryzyka biegunki po probiotyku oraz naturalną ulgę w tych dolegliwościach.

Zakażenia bakteryjne jelita grubego mogą powodować nieprzyjemne objawy, takie jak biegunka, skurcze brzucha i gorączka. Poznaj rodzaje bakterii w jelicie grubym, ich objawy, powikłania i sposoby leczenia.

Dowiedz się, na czym polega badanie żywej kropli krwi i dlaczego warto je wykonać. Ta nieinwazyjna metoda pozwala przyjrzeć się komórkom krwi pod mikroskopem i wykryć potencjalne niedobory oraz nieprawidłowości

Poznaj rodzaje groźnych bakterii układu pokarmowego, objawy infekcji, metody diagnozowania i leczenia chorób jelitowych oraz zapalenia spowodowane przez pasożyty.